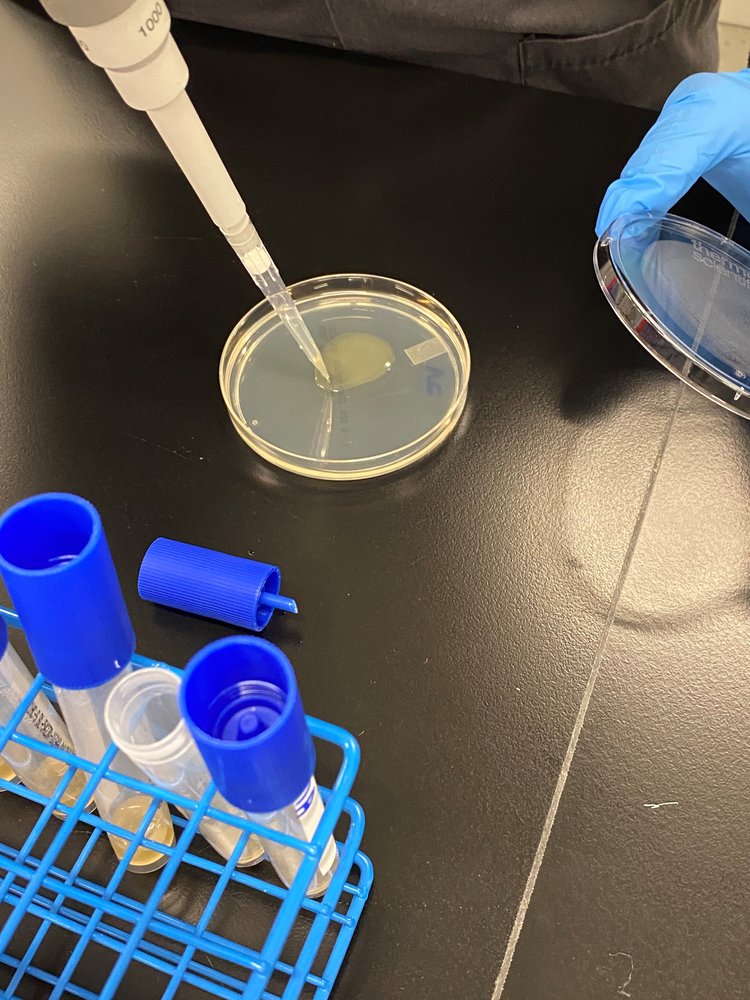

Research
Inside the Innovation- A Comprehensive Study by U.S. Micro-Solutions
-

Inoculation of fasteners with 10 ul of the subtilis suspension
-

Post inoculation- the solution was allowed to dry for 30 minutes
-

Samples cleaned post inoculation with lint free sterile wipes saturated with Peridox RTU
-

Samples being placed in HiCap neutralizing broth and eluted for 1 minute
-

Broth placed in agar plates to be incubated
-

Post 18 hour incubation, samples were analyzed and colony count values were taken

We care about the small details
Flush Fasteners™ offer distinct advantages in the healthcare industry by minimizing potential harbors for bacteria and contaminants due to their streamlined design. Their flush, smooth surfaces facilitate easy cleaning and sterilization processes, crucial for maintaining stringent hygiene standards in medical environments. Additionally, the reduced risk of bacterial buildup on flush head fasteners enhances patient safety and reduces the likelihood of infections, making them an ideal choice for medical equipment and facilities.

Salt Spray Corrosion Test Results
Test Conducted: ASTM B117 Salt Spray Corrosion Test
Testing Facility: Metallurgical Engineering Services, Inc.
Test Duration: 168 Hours
Date Completed: November 5, 2024
Test Overview
Flush Fasteners' stainless steel screws underwent rigorous salt spray testing to evaluate their corrosion resistance under harsh marine conditions. The test was performed per ASTM B117 standards, using a 5% salt solution at an average temperature of 97°F.
Key Findings
-
No red rust observed on Sample 1 and Sample 3 after 168 hours.
-
Minimal corrosion (5% red rust on Sample 2, 10% red rust on Sample 4).
-
All fasteners remained fully functional after exposure.
These results demonstratesuperior corrosion resistance, making Flush Fasteners' screws an ideal choice for marine, industrial, and high-exposure environments.
Why Choose Flush Fasteners?
-
Patented Design
Engineered for durability in extreme conditions.
-
Proven Corrosion Resistance
Outperforms industry standards.
-
Reliable Performance
Maintains full functionality even after prolonged exposure to harsh environments.
For more details or to request samples, contact us today at info@flushfasteners.com